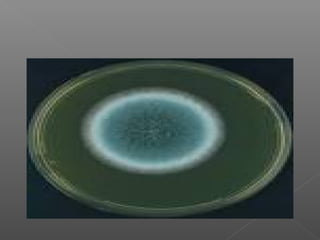

This document summarizes Aspergillus, a ubiquitous fungus with several species that can cause disease in humans. It describes the morphology and life cycle of Aspergillus, noting that its airborne conidia can reach the lungs and cause infection in immunocompromised individuals. It outlines the different clinical forms of aspergillosis, including allergic forms and risk factors. Diagnosis involves microscopy and culture of specimens. Treatment involves antifungal drugs like itraconazole and amphotericin B. Prevention focuses on avoiding exposure to conidia for at-risk groups.